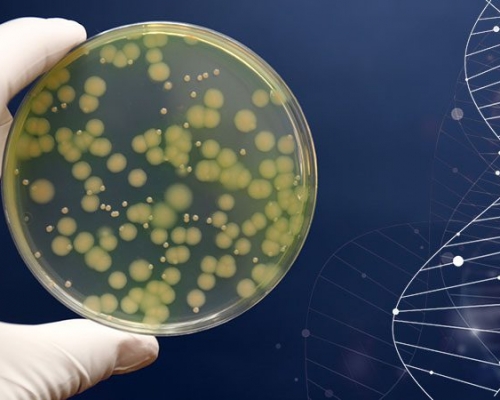

L'Ordine > Tutte le news
Corsi ed eventi
Data pubblicazione: 15/04/2022
Corso base per l’interpretazione dell’Emogas
Il corso ha ricevuto 5 crediti ECM
Corsi ed eventi
Data pubblicazione: 11/04/2022
10° Congresso della Società Internazionale di Medicina di Genere
Padova, 16 e 17 settembre 2022
Corsi ed eventi
Data pubblicazione: 11/04/2022
Scuola di Alta Formazione per Medici di Bordo
Corso Alta Formazione per Medici di Bordo
Corsi ed eventi
Data pubblicazione: 06/04/2022
Point of care ultrasond (POCUS)
Il corso ha ricevuto 18,3 crediti ECM
Elementi in rilievo
Data pubblicazione: 01/04/2022
É il microbioma la nostra chiave di volta?
Integrazione, interprofessionale e multiprofessionale, interistituzionale
Notiziario Medici Chirurghi
Data pubblicazione: 30/03/2022
GRADUATORIE DEFINITIVE CFSMG 2021/2024
Corso di Formazione Specifica in Medicina Generale - triennio 2021/2024. Graduatorie definitive
Corsi ed eventi
Data pubblicazione: 28/03/2022
Emergenze Mediche (EM), Farmacologiche nello studio Odontoiatrico e BLSD
L'evento ha ottenuto 7 crediti ECM - La partecipazione è consentita in una sola data
Corsi ed eventi
Data pubblicazione: 21/03/2022
Risk Management in Sanità
EXECUTIVE MASTER E FORMAZIONE PRO
Corsi ed eventi
Data pubblicazione: 18/03/2022
Management delle lesioni osteolitiche del cavo orale
L'evento si svolge in presenza ed è obbligatorio dimostrare di essere in possesso del Green Pass in corso di validità
Notiziario Medici Chirurghi
Data pubblicazione: 17/03/2022
CFSMG TRIENNIO 2020/2023 - RINUNCIA AL CORSO
Corso di Formazione Specifica in Medicina Generale trienno 2020/2023 - Rinuncia al corso
Corsi ed eventi
Data pubblicazione: 15/03/2022
La trasfusione di sangue: aspetti etici, clinici, organizzativi
Corso ECM "La trasfusione di sangue: aspetti etici, clinici, organizzativi"
Corsi ed eventi
Data pubblicazione: 15/03/2022
Approccio pre ospedaliero al traumatizzato
Corso ECM "Approccio pre ospedaliero al traumatizzato"
Corsi ed eventi
Data pubblicazione: 15/03/2022
I. L. S. Intermediate Life Support
Corso ECM "I.L.S. Intermediate Life Support"
Elementi in rilievo
Data pubblicazione: 11/03/2022
INCONTRI SCIENTIFICI MOSCATIANI
25-26 marzo 2022 - Sala convegni Basilica dello Spirito Santo - Napoli
Corsi ed eventi
Data pubblicazione: 10/03/2022
Approccio biomimetico nelle riabilitazioni estetiche: un viaggio tra l’analogico e il digitale
Crediti ecm 4,9

.jpg)



























